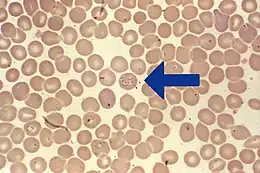
Description de cette image, également commentée ci-après

Babésiose
| Causes | Babesia, Theileria microti (en), Babesia bovis (en) ou Babesia divergens |
|---|---|
| Transmission | Transmission par les tiques (d) |
| Incubation min | 3 j |
| Incubation max | 4 semaine |
| Symptômes | Fatigue, nausée, anorexie, vomissement, myalgie, céphalée, fièvre et dépression |
| Médicament | Quinine, clindamycine, atovaquone et azithromycine |
|---|---|
| Spécialité | Infectiologie |
| CIM-10 | B60.0 |
|---|---|
| DiseasesDB | 1200 |
| eMedicine | 212605 |
| MeSH | D001404 |
| Patient UK | Babesiosis |
![]() Mise en garde médicale
Mise en garde médicale
La babésiose, babésiellose, piroplasmose ou fièvre de Nantucket ou encore fièvre du Texas, est une maladie qui affecte les mammifères sauvages et potentiellement domestiques (bétail ou chiens[1]), et plus rarement l'humain.
C'est une maladie proche du paludisme, provoquée par une Babesia (B. divergens, B. microti), c'est-à-dire un parasite apicomplexe intraérythrocytaire affectant plusieurs espèces. Les babesias semblent toujours ou presque toujours transmises par piqûre de tique.
Chez les bovins, l'espèce impliquée semble généralement être Babesia divergens[2] qui peut affecter des troupeaux entiers de bovins laitiers.
Pathogénie
L'infection cause généralement une anémie hémolytique par destruction des globules rouges.
Le parasite se reproduit en se multipliant de deux en deux agressant le globule, dont la lyse (destruction) relâche les parasites dans le sang.
Historique
Le nom du parasite est attaché à celui de Victor Babeș, qui, en 1888, a le premier publié un article décrivant la présence de microorganismes dans les hématies du bétail atteint d'une maladie fatale se caractérisant par du sang dans les urines et de la fièvre[3]. Le parasite responsable est identifié en 1893[4]. Le premier cas humain est décrit en 1957[5]. Les malades semblent presque toujours être des personnes en état de déficience immunitaire.
Taxonomie, phylogénétique
De nombreuses espèces et variants de Babesia ont été découverts depuis un siècle.
Les progrès de la biologie moléculaire et de la phylogénie de l'espèce ont montré que la classification de certains taxons de Babesia devait être revue[6].
Épidémiologie
.png)
protozoaire responsable de la babésiose.
L'infection se déroule essentiellement durant l'été[7].
Maladie émergente
Comme beaucoup de parasitoses, la babésiose est une maladie due à un parasite dont une population est en permanence entretenue ou renouvelée au sein d'une ou plusieurs espèces-réservoir et transmise par un « vecteur » : l'espèce réservoir est pensait-on constituée de petits rongeurs, mais on a récemment montré que de petits insectivores telles que les musaraignes y contribuent aussi ; selon une étude écoépidémiologique nord américaine publiée en 1990, les musaraignes du genre (Blarina) sont des espèces-réservoir de la babésiose[8] (et de la maladie de Lyme)[8]. Quant au vecteur, il s'agit habituellement d'un arthropode acarien : une tique — remarque : il existe de nombreuses espèces de tiques et toutes ne semblent pas susceptibles de transporter ce parasite. L'espèce porteuse peut changer selon la région.
Comme la maladie de Lyme (qui peut être conjointement transmise par une même tique ou une autre tique dans le cadre d'une co-infection), en raison probablement de déséquilibres écologiques, sylvo-cynégétiques et climatiques ayant favorisé des pullulations de tiques (avec remontée en altitude et vers le nord de l'aire de répartition de ces parasites), en partie à cause du réchauffement climatique, cette maladie est considérée comme maladie émergente[9], notamment en Europe[10], dont en zone de montagne (Suisse par exemple[11], où de plus, des co-infections sont détectées (publication 2006[11]) avec B. sp. EU1-Borrelia burgdorferi sensu stricto[11] et d'autres Babesia sp. EU1-B. afzelii[11]), ou encore avec des Ehrlichias (responsable de l'ehrlichiose[12]).
Maladie mal connue
Il existe plus d'une centaine de Babesias. Seules quelques-unes sont connues comme pouvant infecter l'être humain[13]. Babesia microti est la forme prédominante aux États-Unis et en Extrême-orient. Elle est apparue récemment en France en région parisienne.
Les cas européens sont essentiellement dus à Babesia divergens[14] et moindrement à Babesia duncani et Babesia venatorum ; formes plus rares, mais qui semblent en développement. Les épidémiologistes connaissent encore mal l’incidence et la répartition mondiale des espèces de Babesia, et les effets de la parasitose sur tous les hôtes victimes de ce protozoaire. De plus, dans les zones d’endémie de la malaria, les Babesias peuvent être facilement confondus avec des Plasmodiums.
Difficulté du diagnostic
Les symptômes les plus fréquents de la babésiose sont fatigue, malaises, fièvre avec frissons et céphalées. Plus rarement une altération de l'état mental, hyperesthésie, raideur de la nuque, maux de gorge, douleurs abdominales, nausées, vomissements, injection conjonctivale, essoufflement, et une toux non productive ont été rapportés
Notamment en raison de co-infections possibles avec des borrélies ou d'autres pathogènes, le diagnostic peut être compliqué et erroné. Ainsi, si on sait que la babésiose humaine est causée principalement par B. microti et B. divergens, ces deux parasites protozoaires des globules rouges peuvent être transmis par la tique en même temps que des borrélies responsables de la maladie de Lyme. Dans une partie de l'aire de répartition de ces parasites, la tique Ixodes ricinus (aussi principal vecteur de la maladie de Lyme) peut être infectée par ces deux parasites et les transmettre conjointement à l'Homme.
Les manifestations cliniques varient beaucoup, allant d'une infection asymptomatique à une maladie se développant rapidement et mortelle. Le diagnostic de la babésiose devrait toujours inclure l'examen de frottis sanguin, des tests sérologiques et immunologiques. Le développement de la réaction en chaîne par polymérase (PCR) a amélioré la sensibilité et la fiabilité de la détection, mais ces tests ne sont pas toujours pratiqués, et le sont rarement dans les régions pauvres du monde.
Une co-infection est également possible avec plusieurs espèces de babesia[15]. Une sous-estimation du nombre de cas est donc possible. De plus, des variants nouveaux ont encore été récemment découverts et d'autres sont encore susceptibles de l'être.
Vecteurs
L'espèce de tique vectrice peut différer selon les régions. Mais localement, elle semble être relativement spécifique (au sein du groupe des tiques) ; Par exemple au Japon, parmi d'autres espèces, Ixodes ovatus semble être la principale espèces de tiques porteuses de babesia (l'autre étant I. persulcatus)[16] tandis que dans le nord-est des États-Unis il s'agit d'Ixodes scapularis[17].
Comme dans le cas des borrélies responsables de la maladie de Lyme, les Babesia sont retrouvées dans la salive et les glandes salivaires de la tique vectrice I. ovatus[18], ce qui explique aussi les co-infections, ces deux parasites pouvant peut-être dans ce cas profiter l'un de l'autre (par exemple en affaiblissant l'immunité de l'hôte au moment de l'infection.
Transmission et contamination
Deux modes de contamination sont connus :
- la babésiose semble toujours (ou très majoritairement ?) transmise par une tique. (Babesia microti peut utiliser la même tique vectrice, que la maladie de Lyme Ixodes scapularis, avec co-infections possibles, qui peuvent compliquer le diagnostic.) On l'observe surtout en milieu rural pendant l'été ;
- Dans les zones d’endémie de babésiose, une contamination par transfusion sanguine est également possible[19].
Physiopathologie
Le parasite Babesia se reproduit dans les globules rouges où on peut le voir avec des inclusions en forme de croix : 4 mérozoïtes non différenciés sexuellement mais attachés ensemble et formant une structure semblable à une croix de Malte et provoquant une anémie hémolytique tout à fait semblable à celle de la malaria.
Au contraire du Plasmodium, le parasite qui provoque la malaria, les espèces de Babesia n’ont pas de phase exo-érythrocytaire, aussi le foie n’est-il, habituellement, pas atteint.
Les co-infections sont possibles et probablement assez fréquente (par exemple sur l'île de Nantucket où pour des raisons mal comprises la prévalence de la maladie de Lyme est également très élevée[20]). Il semble qu'une co-infection avec la maladie de Lyme n'aggrave pas ni ne modifie le pronostic médical de cette dernière[21].
Une infection a Babesia peut se manifester par des arthralgies et des maux de tête. Elle provoque également une hyper coagulation. Une labilité émotionnelle peut également être constatée.
Diagnostic
L’infection parasitaire par le Babesia peut être asymptomatique[22] ou se manifester par des symptômes discrets et non spécifiques (fièvre, sueurs, frissons survenant une à quatre semaines après la piqûre de la tique) et beaucoup d'infections ne sont pas répertoriées comme babésiose. Beaucoup de cas, parmi ceux qui sont diagnostiqués, surviennent chez les très jeunes enfants, les personnes très âgées ou les patients en mauvais état général (comme les immunodéficients). Certains cas sont identifiés chez des patients qui sont atteints d’une autre maladie transmise par les tiques, lorsqu’on recherche la babésiose au cours d'un bilan systématique. L'infection peut se manifester par une fatigue prolongée pendant plusieurs mois[13]. Les symptômes sont habituellement peu sévères chez la personne saine. Les formes graves peuvent se compliquer d'un syndrome de détresse respiratoire aiguë ou d'une coagulation intravasculaire disséminée.
La babésiose peut être diagnostiquée à l'examen direct du sang (voir la photo), par la sérologie, ou par les tests basés sur la PCR. Les examens de laboratoire montrent également une diminution du nombre de globules rouges (anémie) et de plaquettes à la numération formule sanguine. L'anémie est de type hémolytique avec augmentation du taux des réticulocytes et diminution du taux sanguin d'haptoglobine.
La recherche de l'ADN parasitaire par PCR est possible[23] et est plus sensible que l'examen direct du sang[24]. Le dosage des anticorps dirigés contre les babesias peut être également fait par technique d'immunofluorescence[25].
En médecine vétérinaire, les signes cliniques les plus souvent observés sont un abattement intense, une fièvre élevée, une anémie, voire un ictère et une hémoglobinurie. Le diagnostic de certitude repose sur la visualisation des Babesias à l'intérieur des globules rouge sur un frottis sanguin réalisé avec du sang provenant de capillaires[1].
Des co-infections avec d'autres maladies à tiques semblent fréquentes. Elles peuvent compliquer le diagnostic et également compliquer et/ou aggraver les symptômes[26]. La recherche systématique d'une maladie de Lyme est recommandée[27].
Non traité, le germe peut persister plusieurs mois, avec des symptômes non spécifiques[28].
Traitement
La prise en charge des babésioses a fait l'objet de la publication de recommandations. Celles de l'« Infectious Diseases Society of America » datent de 2020[29].
La plupart des cas de babésiose guérissent sans traitement spécifique sauf certains patients, dont les porteurs d'une splénectomie, chez qui l'affection peut être grave.
Pour les patients malades, le traitement comporte habituellement l’association de deux molécules :
- le traitement traditionnel par la quinine et la clindamycine est souvent mal toléré[30] ;
- une association de atovaquone et d’azithromycine peut être également efficace[31].
La babésiose est une maladie à déclaration obligatoire au Québec.
Prévention
Après une splénectomie, il est indispensable de prévenir le patient des risques encourus en cas de piqûre de tique.
Dans tous les cas, il est indispensable de s'inspecter minutieusement le corps dès le retour d'une activité en milieu naturel — randonnée, jardinage, etc. — et de retirer le plus tôt possible une tique, à l'aide d'un tire-tique, sans jamais utiliser de produit — éther, huiles, etc. — en raison du risque de régurgitation de la tique. Le risque de transmission d'agents pathogènes à l'hôte augmente proportionnellement avec la durée d'accrochage de la tique[32],[33],[34].
Notes et références
- 1 2 « Babésiose (piroplasmose) du chien et du chat - Babesia canis - ESCCAP France », sur www.esccap.fr (consulté le )
- ↑ Hoch, Goebel, Agoulon, Malandrin (2011) Modélisation de la propagation de Babesia divergens en troupeau bovin laitier, communication à la Réunion annuelle du groupe « Tiques et Maladies à Tiques » (TMT) du Réseau écologie des interactions durables (REID) ; Strasbourg (France) - (2011-11-17 - 2011-11-18 ; Lien
- ↑ V Babes, « Sur l'hémoglobinurie bactérienne du bœuf », C r Acad sci., no 107, , p. 692-694
- ↑ (en) Smith T, Kilborne FL, « Investigations into the nature, causation, and prevention of Texas or southern cattle fever », Department of Agriculture Bureau of Animal Industry bulletin no 1, Washington, DC: Government Printing Office, , p. 177-304
- ↑ (en) Z. Skrabalo, Z. Deanovic, « Piroplasmosis in man : report of a case », Doc méd geogr trop., no 9, , p. 11-16
- ↑ (en) Allsopp MT, Allsopp BA, « Molecular sequence evidence for the reclassification of some Babesia species », Ann N Y Acad Sci., no 1081, , p. 509-17 (PMID 17135560)
- ↑ Gray EB, Herwaldt BL, Babesiosis surveillance — United States, 2011–2015, MMWR Surveill Summ, 2019;68:1-11
- 1 2 (en) Telford III, S. R., Mather, T. N., Adler, G. H., & Spielman, A. (1990) « Short-tailed shrews as reservoirs of the agents of Lyme disease and human babesiosis » The Journal of parasitology, 681-3. (Résumé)
- ↑ (en) C Genchi, « Human babesiosis, an emerging zoonosis », Parassitologia, vol. 49, no Suppl 1, , p. 29-31 (PMID 15787198)
- ↑ (en) JS Gray, « Babesia sp.: emerging intracellular parasites in Europe », Pol J Microbiol., vol. 53, no Suppl, , p. 55-60 (PMID 15787198)
- 1 2 3 4 (en) Casati S, Sager H, Gern L, Piffaretti JC., « Presence of potentially pathogenic Babesia sp. for human in Ixodes ricinus in Switzerland », Ann Agric Environ Med., vol. 13, no 1, , p. 65-70 (PMID 16841874)
- ↑ (en) Hunfeld KP, Hildebrandt A, Gray JS, « Babesiosis: Recent insights into an ancient disease », Int J Parasitol., vol. 38, no 11, , p. 1219–37. (PMID 18440005, DOI 10.1016/j.ijpara.2008.03.001)
- 1 2 (en) Vannier E, Krause PJ, « Human babesiosis », N Engl J Med., no 366, , p. 2397-2407 (lire en ligne)
- ↑ (en) Gray JS, « Identity of the causal agents of human babesiosis in Europe », Int J Med Microbiol., vol. 296, no Suppl 40, , p. 131-6. (PMID 16524772)
- ↑ (en) Cichocka A, Skotarczak B, « Babesosis difficulty of diagnosis », Wiad Parazytol., vol. 47, no 3, , p. 527-33 (PMID 16894770)
- ↑ (en) Zamoto-Niikura A, Tsuji M, Qiang W, Nakao M, Hirata H, Ishihara C, « Detection of two zoonotic Babesia microti lineages, the Hobetsu and U.S. lineages, in two sympatric tick species, Ixodes ovatus and Ixodes persulcatus, respectively, in Japan », Appl Environ Microbiol., vol. 78, no 9, , p. 3424-30 (PMID 22389378)
- ↑ Serge Morand, François Moutou, Céline Richomme et al. (préf. Jacques Blondel), Faune sauvage, biodiversité et santé, quels défis ?, Versailles, Quæ, coll. « Enjeux Sciences », , 190 p. (ISBN 978-2-7592-2202-5, lire en ligne), I. Biodiversité, écologie et maladies infectieuses, chap. 1 (« Quels sont les effets de la biodiversité sur les maladies parasitaires ? »), p. 23, accès libre.
- ↑ (en) Yano Y, Saito-Ito A, Anchalee D, Takada N, « Japanese Babesia microti cytologically detected in salivary glands of naturally infected tick Ixodes ovatus », Microbiol Immunol., vol. 49, no 10, , p. 891-7
- ↑ (en) Gubernot DM, Nakhasi HL, Mied PA, Asher DM, Epstein JS, Kumar S, « Transfusion-transmitted babesiosis in the United States: summary of a workshop », Transfusion, no 49, , p. 2759-2771 (résumé)
- ↑ Ruebush TK, Juranek DD, Spielman A, Piesman J, Healy GR (1981), Epidemiology of human babesiosis on Nantucket Island. Am J Trop Med Hyg ;30:937-41
- ↑ Wang, T. J., Liang, M. H., Sangha, O., Phillips, C. B., Lew, R. A., Wright, E. A.... & Shadick, N. A. (2000), Coexposure to Borrelia burgdorferi and Babesia microti does not worsen the long-term outcome of Lyme disease. Clinical infectious diseases, 31(5), 1149-1154
- ↑ Vannier EG, Diuk-Wasser MA, Ben Mamoun C, Krause PJ, Babesiosis, Infect Dis Clin North Am, 2015;29:357-370
- ↑ (en) Teal AE, Habura A, Ennis J, Keithly JS, Madison-Antenucci S, « A new real-time PCR assay for improved detection of the parasite Babesia microti », J Clin Microbiol., no 50, , p. 903-908 (lire en ligne)
- ↑ Wang G, Villafuerte P, Zhuge J, Visintainer P, Wormser GP, Comparison of a quantitative PCR assay with peripheral blood smear examination for detection and quantitation of Babesia microti infection in humans, Diagn Microbiol Infect Dis, 2015;82:109-113
- ↑ (en) Krause PJ, Ryan R, Telford S III, Persing D, Spielman A, « Efficacy of immunoglobulin M serodiagnostic test for rapid diagnosis of acute babesiosis », J Clin Microbiol., no 34, , p. 2014-2016 (lire en ligne)
- ↑ (en) Krause PJ, Telford III SR, Spielman A, Sikand V, Ryan R, Christianson D et al., « Concurrent Lyme disease and babesiosis evidence for increased severity and duration of illness », JAMA, no 275, , p. 1657-60.
- ↑ Fried JC, Ross JJ, Weiss JF, Levy BD, Loscalzo J, A breathtaking discovery, N Engl J Med, 2023;388:454-459
- ↑ Krause PJ, Spielman A, Telford SR III et al. Persistent parasitemia after acute babesiosis, N Engl J Med, 1998;339:160-165
- ↑ Krause PJ, Auwaerter PG, Bannuru RR et al. Clinical practice guidelines by the Infectious Diseases Society of America (IDSA): 2020 guideline on diagnosis and management of babesiosis, Clin Infect Dis, 2021;72:e49-e64
- ↑ Krause PJ, Lepore T, Sikand VK et al. Atovaquone and azithromycin for the treatment of babesiosis, N Engl J Med, 2000;343:1454-1458
- ↑ (en) Krause P, Lepore T, Sikand V, Gadbaw J, Burke G, Telford S, Brassard P, Pearl D, Azlanzadeh J, Christianson D, McGrath D, Spielman A, « Atovaquone and azithromycin for the treatment of babesiosis », N Engl J Med., vol. 343, no 20, , p. 1454-8 (PMID 11078770)
- ↑ (en) Sood SK, Salzman MB, Johnson BJ, Happ CM, Piesman J et al., « Duration of tick attachment as a predictor of the risk of Lyme disease in an area in which Lyme disease is endemic », J Infect Dis, vol. 175, no 4, , p. 996-9. (PMID 9086168, lire en ligne [PDF])
- ↑ (en) Gammons M, Salam G, « Tick removal », Am Fam Physician, vol. 66, no 4, , p. 643-5. (PMID 12201558, lire en ligne [html])
- ↑ Gétaz L, Loutan L, Mezger N, « Maladies transmises par des tiques d’ici et d’ailleurs [Diseases transmitted by ticks locally and abroad] », Rev Med Suisse, vol. 8, no 340, , p. 974-6. (PMID 22662624, lire en ligne [html])
Articles connexes
- Babésiose du chien
Liens externes
- (en) Babesiosis source d'où provient la première version de cet article.
- Les Babesia : parasites intraérythrocytaires dans le site du Genoscope.
- Portail de la microbiologie
- Portail de la médecine vétérinaire
- Portail de l’hématologie
- Portail de la parasitologie
- Portail de l’élevage